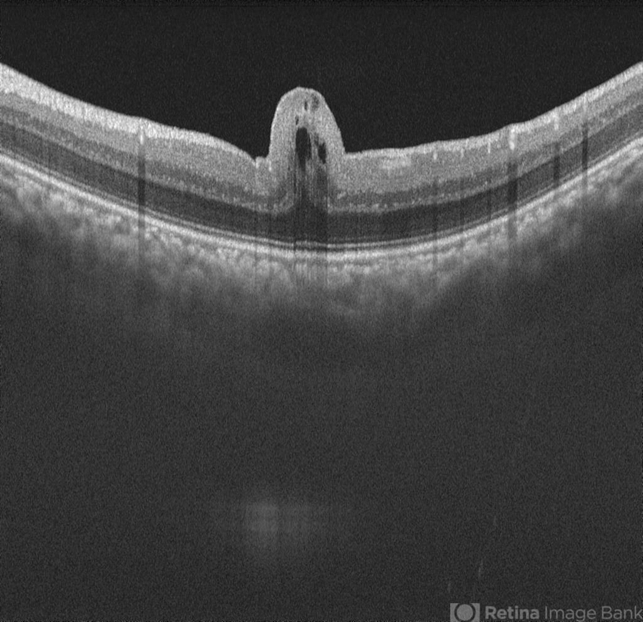

-
 By Hemanth Murthy, MBBS, MD, FASRS
By Hemanth Murthy, MBBS, MD, FASRS
RETINA INSTITUTE OF KARNATAKA
Co-author(s): Dr Prakruthi - Uploaded on Mar 1, 2025.
- Last modified by Joshua Friedman on Mar 3, 2025.
- Rating
- Appears in
- Miscellaneous
- Condition/keywords
- posterior microphthalmos
- Photographer
- Mr Veda Vyas
- Imaging device
- Optical coherence tomography system
- Description
- Swept source OCT image of left eye of 34 year male patient with high hypermetropia(+14). BCVA 20/20 in right eye and 20/60 in left eye. Anterior segment was normal. There is loss of foveal pit with omega shaped elevation of inner retinal layers.

Initializing download.
Initializing download.


